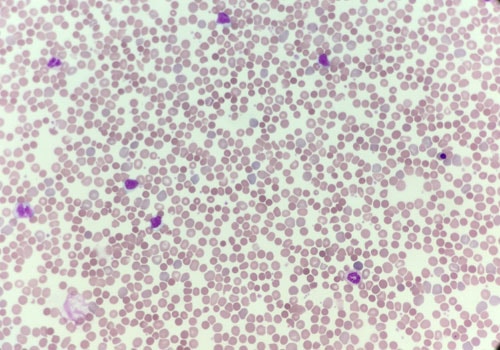
polychromasia
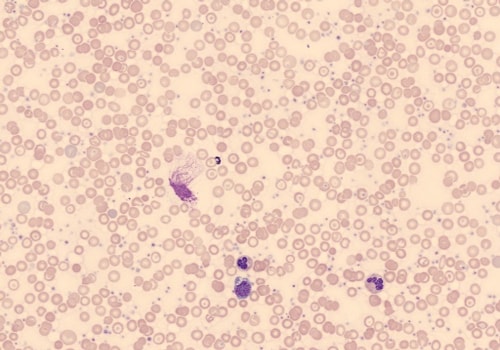
Microcytic Anemia Factor
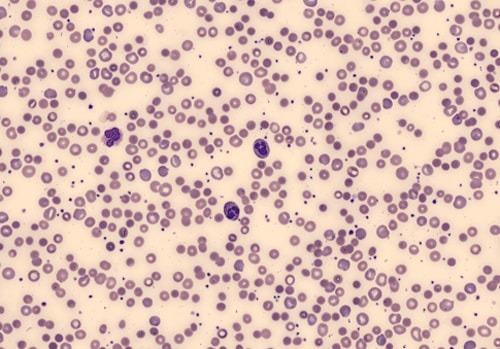
Mean Sphered Cell Volume

What is the Red Blood Cell Size Factor Parameter?
- Red Blood Cell Size Factor (@RSf) may be used to characterize the size of red blood cells across the continuum of cell maturation, including immature and mature erythrocytes
- @RSf is a parameter that combines the volume of erythrocytes and the volume of reticulocytes @RSf = square root (MCV × MRV)
| Parameter |
Method |
Description |
| @RSF |
Calculated |
Red Blood Cell Size Factor
- Characterizes the red cell size
 |
How is @RSf used in research?
- @RSf aids in the assessment of state of erythropoiesis
- Because reticulocytes are larger than RBCs, @RSf increases as the proportion of reticulocytes increases2
 English
English